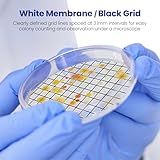
Zoom IMG-2 alwsci filtro a membrana reticolato Zoom IMG-2 alwsci filtro a membrana reticolato

Catalogo Alwsci
Se non hai ancora trovato l'articolo che stai cercando allora consulta il catalogo completo dei prodotti di Alwsci:
-
Alwsci 2ml hplc vials fiale di vetro, laboratorio ambra fiale autocampionat Scheda Completa
Caratteristiche, schede tecniche ed offerte su alwsci 2ml hplc vials fiale di vetro, laboratorio ambra fiale autocampionatore, 9-425 fiala ambra, tappo a vite blu con foro, ptfe blu e bianco silicone septa, 100 pezzi realizzato da ALWSCIPrezzo: 24,99 € (verifica nella scheda prodotto)Fiala Ambra da 2 ml Materiale: Le fiale per autocampionatore con filettatura a vite da 9 mm sono realizzate in vetro borosilicato USP tipo 1, classe B, con coefficiente di espansione molto basso, conforme ai requisiti USP tipo I e ASTM E438, tipo I, classe A. Conforme ai requisiti della Farmacopea statunitense ed europea, migliora la produttività ...
Fiale da laboratorio, Articoli di vetro e per laboratorio, Prodotti scientifici e per laboratorio, Commercio, Industria e Scienza... -
Alwsci 100 pezzi 4ml fiale campione in vetro trasparente bottiglie di campi Scheda Completa
Caratteristiche, schede tecniche ed offerte su alwsci 100 pezzi 4ml fiale campione in vetro trasparente bottiglie di campionamento 13-425 tappo pp nero chiuso, fodera pe contenitore campione fiala laboratorio 15x45mm realizzato da ALWSCIPrezzo: 39,99 € (verifica nella scheda prodotto)Vetro di Alta Qualità: queste fiale sono realizzate in vetro borosilicato trasparente, classe B, tipo 1, caratterizzato da un'eccellente resistenza chimica, proprietà termiche e chiarezza., Tappi a Vite Neri: Tutti i flaconi sono forniti con tappi a vite in polipropilene nero e rivestimenti in PE. L'imbottitura in PE all'interno del tappo di plas...
Fiale da laboratorio, Articoli di vetro e per laboratorio, Prodotti scientifici e per laboratorio, Commercio, Industria e Scienza... -
Alwsci 2ml contenitori portafiale, vassoio per fiale autocampionate con 50 Scheda Completa
Caratteristiche, schede tecniche ed offerte su alwsci 2ml contenitori portafiale, vassoio per fiale autocampionate con 50 scomparti, impilabile, flaconcini per fiale da 1,5 ml-2 ml, per provette da centrifuga realizzato da ALWSCIPrezzo: 32,99 € (verifica nella scheda prodotto)Cestello per Fiale da 2 mL: ideale per fiale HPLC Autosampler da 2 ml con diametro di 12 mm e altre provette di dimensioni simili, come le fiale criogeniche da 1,5 ml/1,8 ml/2 ml e le provette da centrifuga., Risparmiare Spazio: Il rack di fiale può essere impilato nel vuoto o riempito con un set di fiale, risparmiando spazio impilando molti rack ...
Portaprovette da laboratorio, Scaffali da laboratorio, Arredi da laboratorio, Prodotti scientifici e per laboratorio, Commercio, Industria e Scienza... -
Alwsci 100ml bottiglia di vetro a bocca larga in vetro ambrato con tappo a Scheda Completa
Caratteristiche, schede tecniche ed offerte su alwsci 100ml bottiglia di vetro a bocca larga in vetro ambrato con tappo a vite in polietilene nero rivestito in pe septa 50x87.5mm, confezione da 24 realizzato da ALWSCIPrezzo: 68,99 € (verifica nella scheda prodotto)Materiale del flacone Paker: Il nostro flacone Paker a bocca larga è realizzato in vetro sodo-calcico ambrato conforme ai requisiti USP III; compatibilità con le soluzioni, versatilità, resistenza al calore, ai gas e ai vapori e protezione dai raggi UV per i campioni sensibili alla luce., Tappo a vite nero: Questi contenitori hanno un coperchio ...
Bottiglie per analisi ambientali, Bottiglie e contenitori da laboratorio, Articoli di vetro e per laboratorio, Prodotti scientifici e per laboratorio, Commercio, Industria e Scienza... -
Alwsci 2 pezzi 50 ml matraccio volumetrico matracci tarati da laboratorio c Scheda Completa
Caratteristiche, schede tecniche ed offerte su alwsci 2 pezzi 50 ml matraccio volumetrico matracci tarati da laboratorio con tappo in vetro, vetro borosilicato 3.3, classe a, matraccio graduato per laboratorio realizzato da ALWSCIPrezzo: 29,99 € (verifica nella scheda prodotto)Materiale premium: volumetrici Flasks sono realizzati in vetro borosilicato 3.3 di alta qualità. Tolleranza di classe A, come standard ASTM E296. La superficie traslucida offre una buona osservazione durante l'uso., Scala chiara: più facile identificare la linea di scala standard, per una misurazione accurata, più facile da controllare la sostan...
Matracci tarati da laboratorio, Matracci da laboratorio, Articoli di vetro e per laboratorio, Prodotti scientifici e per laboratorio, Commercio, Industria e Scienza... -
Alwsci 144 pezzi flaconi campioni vetro 4ml chiare fiale di vetro bottiglie Scheda Completa
Caratteristiche, schede tecniche ed offerte su alwsci 144 pezzi flaconi campioni vetro 4ml chiare fiale di vetro bottiglie di campionamento con tappo a vite, naturale ptfe/bianco silicone liner contenitori di campione laboratorio 15x45mm realizzato da ALWSCIPrezzo: 54,99 € (verifica nella scheda prodotto)Vetro di Alta Qualità: Queste fiale sono realizzate in vetro borosilicato trasparente di tipo 1, classe B, caratterizzato da un'eccellente resistenza chimica, proprietà termiche e chiarezza., Tappi a Vite Neri: Tutte le fiale sono dotate di tappi a vite in polipropilene nero e rivestimento in PTFE naturale/ silicone bianco. resistenti alla corros...
Fiale da laboratorio, Articoli di vetro e per laboratorio, Prodotti scientifici e per laboratorio, Commercio, Industria e Scienza... -
Alwsci 24 pezzi bottigliette per oli essenziali, bottiglie 30 ml con pipett Scheda Completa
Caratteristiche, schede tecniche ed offerte su alwsci 24 pezzi bottigliette per oli essenziali, bottiglie 30 ml con pipetta marrone bottiglie contagocce vetro per laboratorio, olio essenziale, aromaterapia realizzato da ALWSCIPrezzo: 32,99 € (verifica nella scheda prodotto)Materiale di alta qualità: queste bottiglie contagocce per oli essenziali sono realizzate in robusto vetro ambrato, coperchi in plastica nera spessa e top in silicone resistente alla corrosione; queste bottiglie di vetro ambrato potrebbero proteggere i liquidi dalla luce UV. È perfetto per realizzare miscele di oli essenziali fai da te e miscele ...
Bottiglie contagocce da laboratorio, Bottiglie e contenitori da laboratorio, Articoli di vetro e per laboratorio, Prodotti scientifici e per laboratorio, Commercio, Industria e Scienza... -
Alwsci 1ml fiale per campioni di vetro 8x40 mm base piatta fiala a conchigl Scheda Completa
Caratteristiche, schede tecniche ed offerte su alwsci 1ml fiale per campioni di vetro 8x40 mm base piatta fiala a conchiglia in vetro trasparente con tappo. 200pz/pz. realizzato da ALWSCIPrezzo: 35,99 € (verifica nella scheda prodotto)Materiale: Vetro borosilicato UPS Tipo1 Classe B, Dimensioni: Altezza 40 mm x Diametro 8 mm, Volume utilizzabile 1,0 ml, volume residuo <80 µl, volume di lavoro min. Volume di lavoro 100 µl, Volume di riempimento totale 1,4 ml, Il tappo in polietilene con design a stella facilita la penetrazione dell'ago della siringa, Applicazioni: Le fiale a co...
Fiale da laboratorio, Articoli di vetro e per laboratorio, Prodotti scientifici e per laboratorio, Commercio, Industria e Scienza... -
Alwsci flaconcini hplc da 2 ml, fiale laboratorio fiale trasparenti per aut Scheda Completa
Caratteristiche, schede tecniche ed offerte su alwsci flaconcini hplc da 2 ml, fiale laboratorio fiale trasparenti per autocampionatori da laboratorio, fiala trasparente 9-425, tappo a vite blu, setti in silicone bianco ptfe e rosso, 100 pz realizzato da ALWSCIPrezzo: 26,99 € (verifica nella scheda prodotto)Materiale della Fiala Trasparente da 2 mL: Le fiale per autocampionatore con filettatura a vite da 9 mm sono realizzate in vetro borosilicato USP tipo 1, classe B, con un coefficiente di espansione molto basso, conforme ai requisiti USP tipo I e ASTM E438, tipo I, classe A. Conforme ai requisiti della Farmacopea statunitense ed europea, migliora la...
Fiale da laboratorio, Articoli di vetro e per laboratorio, Prodotti scientifici e per laboratorio, Commercio, Industria e Scienza... -
Alwsci filtro a membrana, filtro a membrana reticolato, diametro: 47 mm, po Scheda Completa
Caratteristiche, schede tecniche ed offerte su alwsci filtro a membrana, filtro a membrana reticolato, diametro: 47 mm, pori: 0,22um, confezione singola da 100 pz. realizzato da LabfilPrezzo: 36,99 € (verifica nella scheda prodotto)I filtri a membrana MCE da 0,22 um di Labfil sono utilizzati principalmente per la filtrazione in laboratorio, Il filtro a membrana MCE è caratterizzato da una superficie più liscia e uniforme rispetto al filtro in nitrocellulosa pura, I filtri grigliati hanno linee di griglia chiaramente definite e distanziate da intervalli di 3,1 mm. Diametro: ...
Filtri a membrana da laboratorio, Filtri da laboratorio, Prodotti di filtrazione, Commercio, Industria e Scienza... -
Alwsci 100 ml reagente media stoccaggio bottiglia di reagenti di laboratori Scheda Completa
Caratteristiche, schede tecniche ed offerte su alwsci 100 ml reagente media stoccaggio bottiglia di reagenti di laboratorio con tappo a vite blu gl 45, vetro borosilicato 3.3, confezione da 1 realizzato da ALWSCIPrezzo: 21,99 € (verifica nella scheda prodotto)Bottiglia per impieghi gravosi: Questa bottiglia per la conservazione dei supporti è realizzata in tubi di borosilicato 3.3 di elevata purezza e chiarezza, il vetro borosilicato ha una buona resistenza al fuoco e una buona resistenza; può essere utilizzata per la conservazione a lungo termine e per la miscelazione e il campionamento., Autoclavabi...
Bottiglie per reagenti da laboratorio, Bottiglie e contenitori da laboratorio, Articoli di vetro e per laboratorio, Prodotti scientifici e per laboratorio, Commercio, Industria e Scienza... -
Alwsci 20 pezzi 30mlfiale di vetro fiale laboratorio bottiglie di campionam Scheda Completa
Caratteristiche, schede tecniche ed offerte su alwsci 20 pezzi 30mlfiale di vetro fiale laboratorio bottiglie di campionamento nero chiuso tappo pp, pe liner laboratorio fiala 27.5x84mm realizzato da ALWSCIPrezzo: 24,99 € (verifica nella scheda prodotto)Vetro di alta qualità: questi flaconi sono realizzati in vetro borosilicato di tipo 1 classe B, che si caratterizza per un'eccellente resistenza chimica, proprietà termiche e una chiarezza eccezionali', Tappi a vite neri: tutti i flaconi sono dotati di tappi a vite neri in polipropilene e pellicola di polietilene. Il cuscinetto in polietilene all...
Fiale da laboratorio, Articoli di vetro e per laboratorio, Prodotti scientifici e per laboratorio, Commercio, Industria e Scienza... -
Alwsci 20 pezzi 10 ml vetro campione fiale bottiglie di campionamento nero Scheda Completa
Caratteristiche, schede tecniche ed offerte su alwsci 20 pezzi 10 ml vetro campione fiale bottiglie di campionamento nero chiuso tappo pp, pe liner contenitori di campione laboratorio fiala 22x52mm realizzato da ALWSCIPrezzo: 19,99 € (verifica nella scheda prodotto)Vetro di alta qualità: queste fiale sono realizzate in vetro borosilicato di tipo 1 classe B, caratterizzato da un'eccellente resistenza chimica, proprietà termiche e chiarezza, Tappi a vite neri: tutti i flaconcini sono forniti con tappi a vite neri in polipropilene e pellicola PE. Il cuscinetto in PE all'interno del tappo di plastica può forma...
Fiale da laboratorio, Articoli di vetro e per laboratorio, Prodotti scientifici e per laboratorio, Commercio, Industria e Scienza... -
Tappo a crimpare in alluminio da 20 mm, guarnizione a crimpare in alluminio Scheda Completa
Caratteristiche, schede tecniche ed offerte su tappo a crimpare in alluminio da 20 mm, guarnizione a crimpare in alluminio con setti in ptfe naturale/silicone bianco per fiale per spazio di testa (confezione da 100) realizzato da ALWSCIPrezzo: 36,99 € (verifica nella scheda prodotto)Tappi in Alluminio: Questi tappi in alluminio comprendono tappi e setti in alluminio (PTFE naturale da 20 mm/Setto in silicone bianco da 3 mm di spessore) compatibili con le fiale per spazio di testa a crimpare ALWSCI., Materiale di Alta Qualità: Resistente a temperature da 60°C a 200°C; questo setto in PTFE/Silicone con PTFE chimicamente inerte...
Tappi per articoli da laboratorio, Articoli di vetro e per laboratorio, Prodotti scientifici e per laboratorio, Commercio, Industria e Scienza... -
Alwsci 2ml hplc vials fiale in polipropilene, fiale per autocampionatore da Scheda Completa
Caratteristiche, schede tecniche ed offerte su alwsci 2ml hplc vials fiale in polipropilene, fiale per autocampionatore da laboratorio, fiala trasparente 9-425, tappo a vite blu con foro, setti in silicone bianco ptfe e rosso, 100 pz realizzato da ALWSCIPrezzo: 25,99 € (verifica nella scheda prodotto)Materiale della fiala trasparente: Le fiale per autocampionatore con filettatura a vite da 9 mm sono realizzate in polipropilene; le fiale in polipropilene sono un'alternativa economica al vetro per alcune applicazioni., Tappi a vite blu: Queste fiale in polipropilene sono dotate di tappo a vite e setti in ABS blu (PTFE bianco/rivestimento in silic...
Fiale da laboratorio, Articoli di vetro e per laboratorio, Prodotti scientifici e per laboratorio, Commercio, Industria e Scienza... -
Alwsci 8 ml fiale del campione 20pcs flaconcini in vetro trasparente, fiala Scheda Completa
Caratteristiche, schede tecniche ed offerte su alwsci 8 ml fiale del campione 20pcs flaconcini in vetro trasparente, fiala per campioni liquidi con tappi a vite, contenitori del campione della fodera del pe fiala del laboratorio realizzato da ALWSCIPrezzo: 19,99 € (verifica nella scheda prodotto)Vetro di alta qualità: Queste fiale sono realizzate in vetro borosilicato trasparente di tipo 1, classe B, caratterizzato da un'eccellente resistenza chimica, proprietà termiche e trasparenza., Facile da trasportare: Ideale per l'uso generale in laboratorio e per la conservazione dei campioni. Queste fiale sono perfette per i viaggi e si adattano...
Fiale da laboratorio, Articoli di vetro e per laboratorio, Prodotti scientifici e per laboratorio, Commercio, Industria e Scienza... -
Alwsci tappo per fiale per autocampionatore 9-425, tappi a vite in poliprop Scheda Completa
Caratteristiche, schede tecniche ed offerte su alwsci tappo per fiale per autocampionatore 9-425, tappi a vite in polipropilene blu da 9 mm con setti in ptfe rosso/silicone bianco, 100 pezzi/pz. realizzato da ALWSCIPrezzo: 17,99 € (verifica nella scheda prodotto)Tappi a Vite Blu: Queste fiale per autocampionatore da 2 ml sono dotate di tappo a vite in ABS blu e di setti (PTFE rosso/supporto in silicone bianco) compatibili con la maggior parte delle fiale per autocampionatore., Materiale di Alta Qualità: Questo setto in PTFE/Silicone con PTFE chimicamente inerte prima di essere penetrato e con la più fort...
Fiale da laboratorio, Articoli di vetro e per laboratorio, Prodotti scientifici e per laboratorio, Commercio, Industria e Scienza... -
Alwsci 250ml bottiglia di lavaggio del gas del laboratorio, bottiglia gradu Scheda Completa
Caratteristiche, schede tecniche ed offerte su alwsci 250ml bottiglia di lavaggio del gas del laboratorio, bottiglia graduata del laboratorio con gl45 tappo a vite rosso del polipropilene gl45, 1set realizzato da ALWSCIPrezzo: 43,99 € (verifica nella scheda prodotto)Materiale di Vetro Superiore: Questa bottiglia per il lavaggio dei gas da laboratorio è realizzata in vetro borosilicato di elevata purezza e trasparenza, con spessore uniforme delle pareti e basso coefficiente di espansione termica., Spessore della Parete: La bottiglia tampone con tappo a vite resistente alla pressione è strettamente sigillata, ...
Bottiglie di lavaggio da laboratorio, Bottiglie e contenitori da laboratorio, Articoli di vetro e per laboratorio, Prodotti scientifici e per laboratorio, Commercio, Industria e Scienza... -
Alwsci 100 pezzi 20ml fiale di campione di vetro trasparente bottiglie di c Scheda Completa
Caratteristiche, schede tecniche ed offerte su alwsci 100 pezzi 20ml fiale di campione di vetro trasparente bottiglie di campionamento 24-400 nero tappo superiore chiuso pp, pe liner fiale di laboratorio contenitore di campione 27,5x57mm realizzato da ALWSCIPrezzo: 52,99 € (verifica nella scheda prodotto)Vetro di Alta Qualità: queste fiale sono realizzate in vetro borosilicato trasparente, classe B, tipo 1, che presenta un'eccellente resistenza chimica, proprietà termiche e chiarezza., Tappi a Vite Neri: Tutti i flaconi sono forniti con tappi a vite neri in polipropilene e film PE. L'imbottitura in PE all'interno del tappo di plastica è in grado...
Fiale da laboratorio, Articoli di vetro e per laboratorio, Prodotti scientifici e per laboratorio, Commercio, Industria e Scienza... -
Alwsci 4ml porta fiale contenitori portafiale, vassoio per fiale autocampio Scheda Completa
Caratteristiche, schede tecniche ed offerte su alwsci 4ml porta fiale contenitori portafiale, vassoio per fiale autocampionate con 50 scomparti, impilabile, flaconcini per fiale per fiale da 4 ml realizzato da ALWSCIPrezzo: 16,99 € (verifica nella scheda prodotto)Resistenza alla corrosione: la struttura del tubo della centrifuga è realizzata in polipropilene, resistente agli acidi, agli alcali e ai vari solventi organici, Dimensioni: L 8,5 '' * W 4,5 '' * H 1 '', 50 fori. Diametro del foro: 16 mm per 50 provette da 4 ml con diametro esterno inferiore a 16 mm, Contenitore per fiale da 4 ml: ideale per flaco...
Portabottiglie da laboratorio, Scaffali da laboratorio, Arredi da laboratorio, Prodotti scientifici e per laboratorio, Commercio, Industria e Scienza...